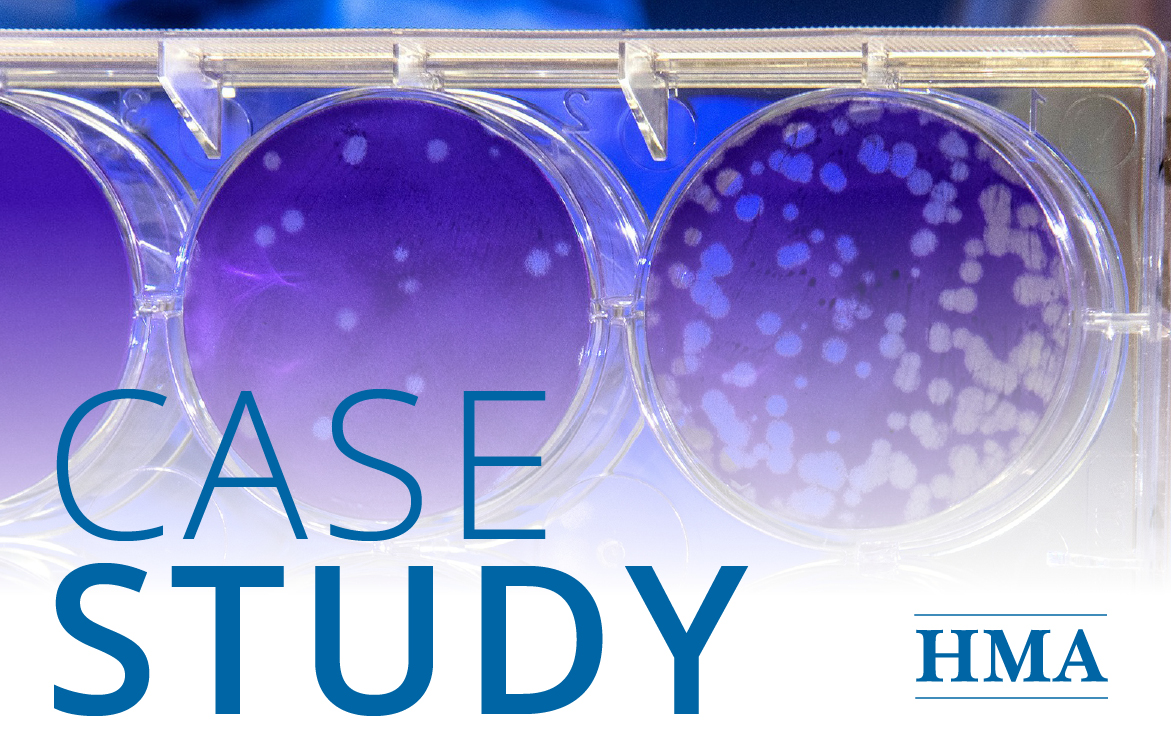
Ensuring Appropriate Payment for Transformative Therapies to Secure Patient Access to CAR Ts

THE CLIENT
A major pharmaceutical manufacturer was preparing to launch a new oncology drug. This drug, a self-administered oral drug with a multi-week dosing regimen, was provided through the pharmacy benefit. The client was concerned about patients not being able to access the drug at hospitals and in post-acute care settings, where institutions received bundled payment for the care.
BACKGROUND
Bundled payment can serve as a disincentive to provide high-cost drugs, so the client was interested in pursuing reimbursement policy options that would ensure appropriate reimbursement to these facilities, thus ensuring patient access to the drug during the treatment regimen.
APPROACH
HMA helps physician associations, device manufacturers, and drug companies understand billing practices, reimbursement challenges, and patient outcomes, enabling them to make informed decisions.
For this analysis, the client wanted to learn about the likelihood that patients receiving their cancer treatment would be admitted to the hospital and then to other post-acute settings during the treatment window. Using our in-house library of Medicare claims data including claims for inpatient, outpatient, physician office, skilled nursing facility, home health, and other post-acute settings, we tracked patients with the specific cancer from diagnosis forward for several months. We were able to see how often patients were hospitalized, what prompted the hospitalization, how many were discharged for post-acute care, and how long treatment continued.
Our analysis provided data-driven insights that supported the client’s strategic decision-making and planning. Using the information from our claims analysis and overlaying the typical treatment regimen under the new cancer drug, the client was able to determine where their patients might face barriers to treatment. For example, most drugs provided in the inpatient setting are bundled into the payment the hospital receives, giving hospitals a disincentive to provide higher cost drugs. While the number of patients receiving their drug that would likely be admitted to the hospital during the treatment period was not high, the company wanted to remove as many barriers to access as possible, and is now considering pursuing a new technology add-on payment (NTAP) for the drug when used in the inpatient setting. The claims analysis also found that some of the cancer patients of interest receive home health care during the treatment window, but since patients are able to continue to receive drugs through their pharmacy benefit while also receiving home health care, the patients would be able to continue their oncology treatment. The patient journey analysis allowed the company to focus attention on settings where access could potentially be disrupted, to ensure that patients are able to continue their cancer treatment.
RESULTS
We identified patients with this specific type of cancer and tracked these patients to see how often they accessed different care settings and identified any potential reimbursement challenges. We further analyzed the volume of patients of interest receiving care in each setting and calculated the average cost per user within the approximate dosing regimen. This allowed us to identify any reimbursement risks for the drug associated with each care setting. Armed with concrete information on the treatment path of these oncology patients, the client was able to make an informed decision about whether to pursue an NTAP for inpatient use of their drug. The company was also able to educate providers and patients providing information on both the benefits of the new treatment, and the reimbursement scenarios in the various care settings.